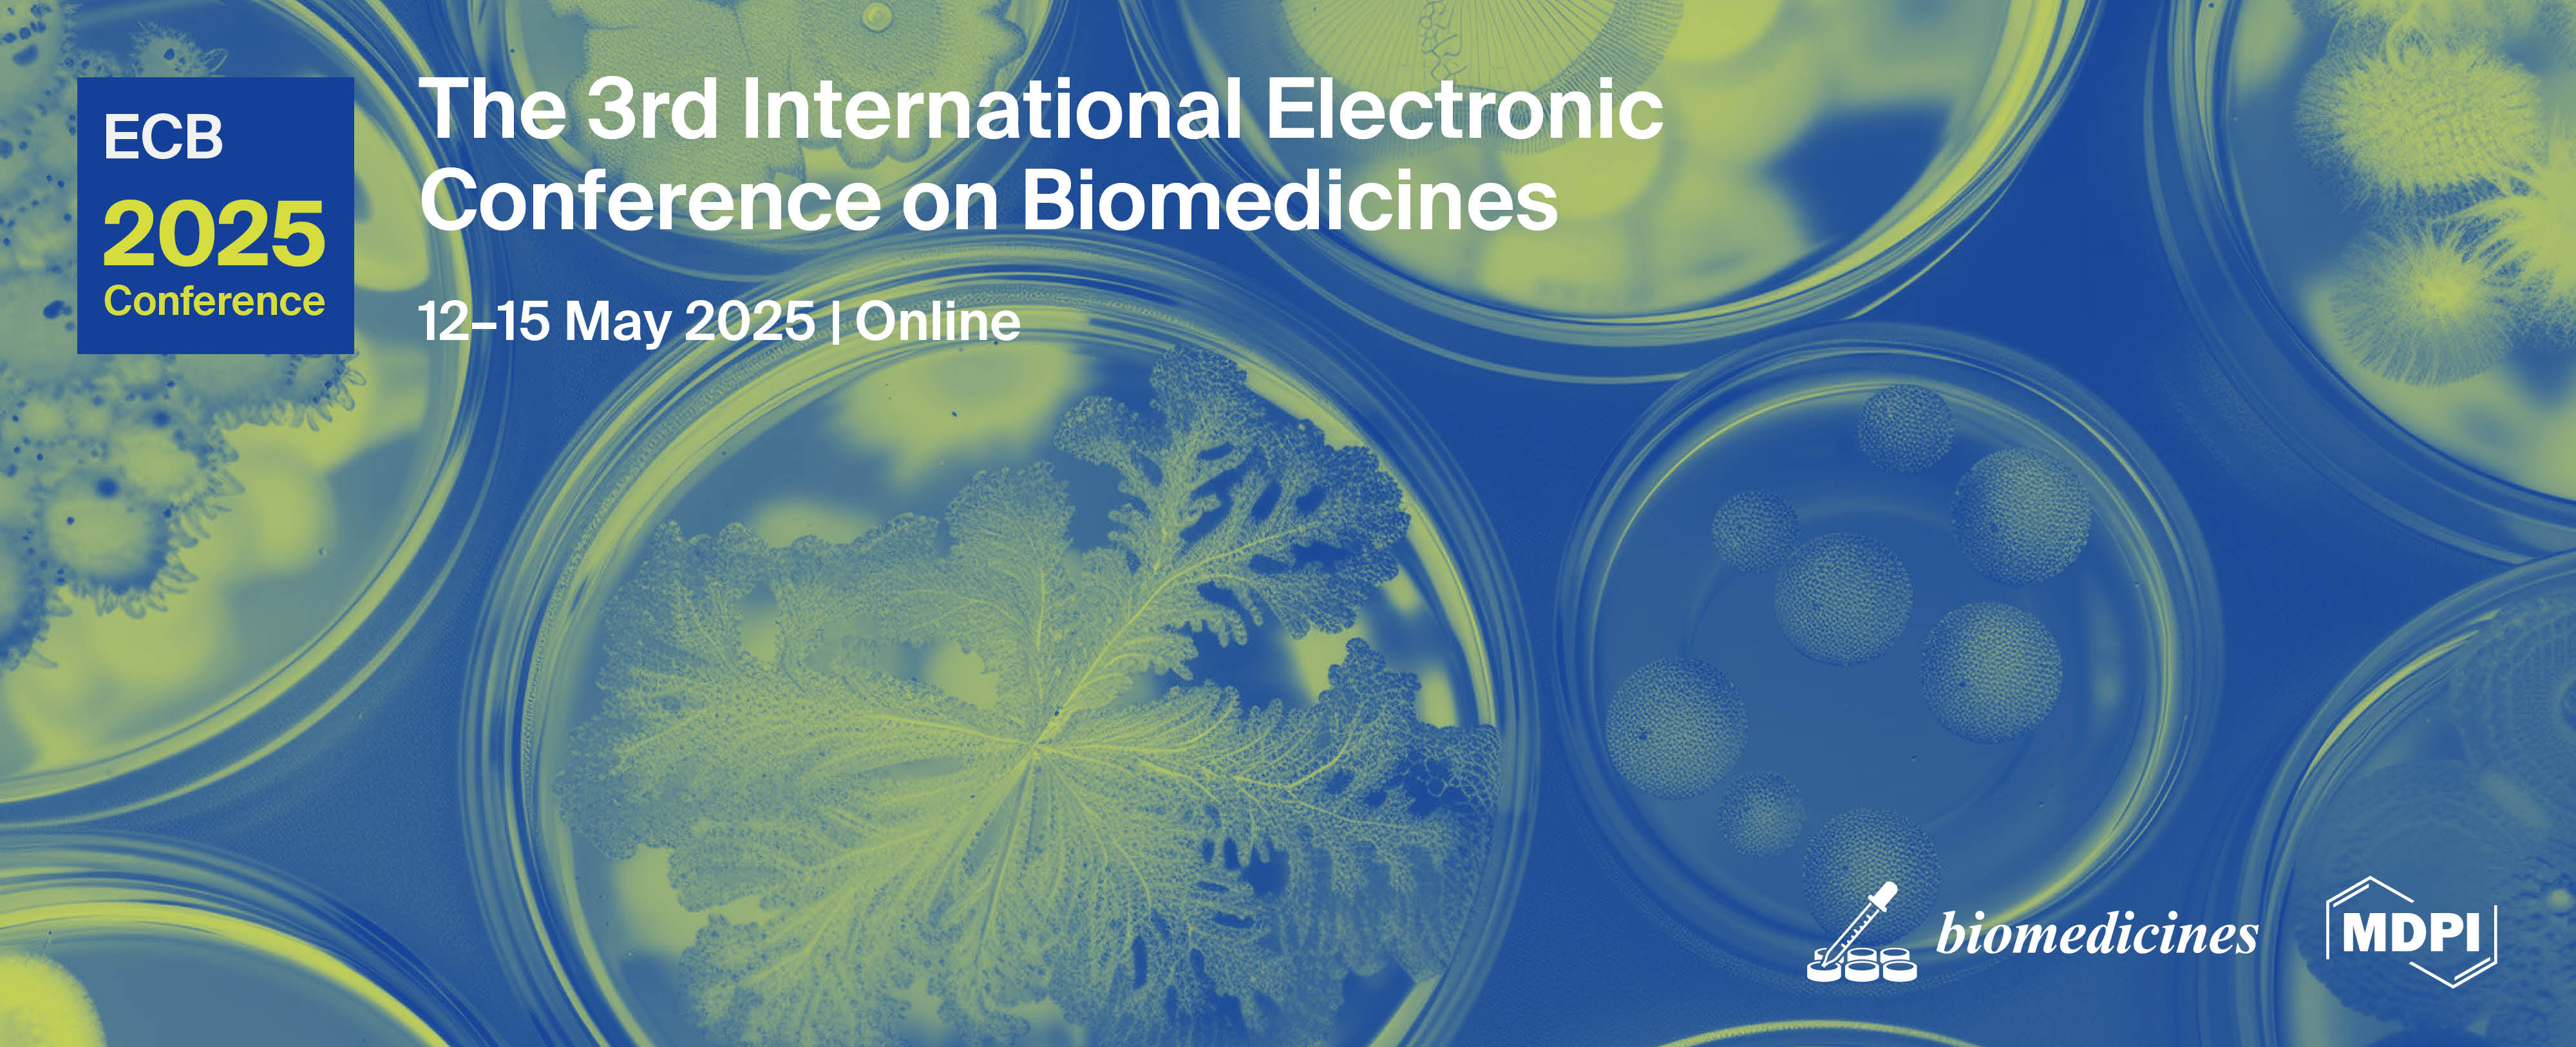
Meet Us Online at the 3rd International Electronic Conference on Biomedicines, 12–15 May 2025

Meet Us Online at the 3rd International Electronic Conference on Biomedicines, 12–15 May 2025
Conference: 3rd International Electronic Conference on Biomedicines
Time: 12–15 May 2025, CEST, Online
Website: https://sciforum.net/event/ECB2025
We cordially invite you to attend the above event organized by the MDPI journal Biomedicines (ISSN: 2227-9059; Impact Factor: 3.9). The conference will take place virtually on 12–15 May 2025, CEST.
Conference Chairs:
- Prof. Dr. Felipe Fregni, Harvard Medical School, Boston, MA, USA;
- Prof. Dr. Allan Stensballe, Aalborg University, Aalborg, Denmark;
- Prof. Dr. Georgia Levidou, Paracelsus Medical University, Klinikum Nuremberg, Germany;
- Prof. Dr. Serafino Fazio, Federico II University School of Medicine, Naples, Italy.
The Topics of Interest:
S1. Insulin resistance or hyperinsulinemia;
S2. Immunotherapy and adverse effects;
S3. Tumor microenvironment;
S4. Immune system, tumor immunology, and autoimmune disease;
S5. Biomedicine in cardiovascular diseases;
S6. Diabetes, obesity and metabolic diseases;
S7. Gene therapy and gene editing;
S8. Rare diseases;
S9. Molecular mechanisms of neurodegeneration.
Important Dates:
Deadline for abstract submission: 19 January 2025;
Notification of acceptance: 19 February 2025;
Deadline for free registration: 8 May 2025.
Submit your abstract here.
Register for the conference here.
For any inquiries regarding the event, please contact ecb@mdpi.com. We look forward to seeing you at ECB2025.